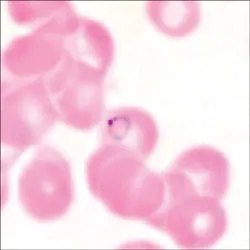
Hỏi – đáp về bệnh sốt rét

HỎI: Tại sao ta bị bệnh sốt rét?
Ký sinh trùng sốt rét Plasmodium falciparum trong hồng cầu (dạng hình nhẫn).
ĐÁP: Bệnh sốt rét do một loại sinh vật rất nhỏ ký sinh trong hồng cầu gây nên, được gọi là ký sinh trùng sốt rét, tên khoa học gọi là Plasmodium. Có 4 loại ký sinh trùng sốt rét gây bệnh ở người, trong đó Plasmodium falciparum được chú ý nhất vì có thể gây sốt rét ác tính chết người và sốt rét kháng thuốc, kế đến là Plasmodium vivax vì hay gây sốt rét tái phát. Bệnh sốt rét lây truyền khi muỗi A-nô-phen (còn gọi là muỗi đòn xóc) có mang ký sinh trùng sốt rét đốt người. Bệnh sốt rét cũng có thể lây truyền qua các con đường khác tuy hiếm gặp hơn như: qua truyền máu, qua kim tiêm có nhiễm ký sinh trùng sốt rét, hoặc qua nhau thai từ bà mẹ bị sốt rét (sốt rét bẩm sinh).
- Bệnh sốt rét gây tác hại gì?
- Sốt rét là bệnh ai cũng có thể mắc. Đừng xem thường bệnh sốt rét vì bệnh có thể gây chết người, nhất là ở trẻ em, phụ nữ có thai, người chưa có miễn dịch với sốt rét. Bệnh sốt rét kéo dài gây thiếu máu, sức khỏe suy mòn, gan lách sưng to, phụ nữ kinh nguyệt không đều, dễ sẩy thai, đẻ non. Bệnh sốt rét ảnh hưởng đến lao động, học tập, sản xuất, giảm thu nhập kinh tế, tác động xấu đến sự phát triển kinh tế, xã hội của đất nước.
- Làm thế nào để không mắc bệnh sốt rét?
- Biện pháp đơn giản và hiệu quả nhất là không để muỗi đốt bằng cách ngủ mùng, nhất là mùng có tẩm hóa chất xua và diệt muỗi. Nếu có điều kiện thì các cửa phòng nên đóng lưới để ngăn cản muỗi bay vào. Ngoài ra, có thể hạn chế muỗi đốt bằng cách: mặc quần, áo dài tay lúc chiều tối; áp dụng các biện pháp xua muỗi như: nhang xua muỗi hoặc bôi thuốc xua muỗi. Cần vệ sinh nhà ở và môi trường để muỗi không có chỗ trú ẩn và sinh đẻ. Uống thuốc phòng chỉ là biện pháp tình thế và không bảo đảm hoàn toàn sẽ không mắc bệnh sốt rét.
- Bệnh sốt rét có những biểu hiện nào?
- Sốt là triệu chứng quan trọng nhất. Cơn sốt rét có thể là điển hình với các dấu hiệu xuất hiện theo thứ tự: rét run – sốt nóng – ra mồ hôi. Có cơn sốt không điển hình như: sốt không thành cơn, chỉ ớn lạnh, gai rét, thường gặp ở trẻ em và người sống lâu ở vùng sốt rét lưu hành; hoặc sốt liên tục hoặc dao động trong 5 – 7 ngày đầu, rồi thành cơn (ở bệnh nhân bị sốt rét lần đầu). Những dấu hiệu khác có thể gặp: thiếu máu, lách to... Hãy nghĩ đến sốt rét nếu bạn bị sốt trong vòng ít nhất 1 tuần kể từ khi bạn đi vào vùng sốt rét. Tuy nhiên, vì sốt cũng là dấu hiệu của nhiều bệnh khác nên việc xét nghiệm máu là cần thiết để có được chẩn đoán chính xác hơn.
- Khi nghi ngờ bị sốt rét ta phải làm gì?
- Phải nhanh chóng đến cơ sở y tế gần nhất để được khám bệnh và xét nghiệm máu. Xét nghiệm máu giúp tìm ra loài ký sinh trùng gây bệnh để điều trị thuốc thích hợp. Hiện nay, bên cạnh xét nghiệm lam máu tìm ký sinh trùng sốt rét qua kính hiển vi quang học, có thể dùng các Test chẩn đoán nhanh để xác định ký sinh trùng sốt rét trước khi điều trị. Điều trị đúng thuốc, đúng liều, đủ thời gian sẽ chữa khỏi hẳn bệnh sốt rét. Hiện nay các thuốc sốt rét thuộc Dự án quốc gia phòng chống sốt rét đều được cấp miễn phí tại các cơ sở y tế Nhà nước.
BS THÀNH Ý
(Viện Sốt rét-KST-CT TPHCM)

























